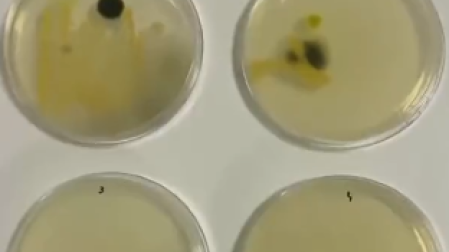
thumb

¿Limpias las latas con tu ropa? mira cuántas bacterias hay en la parte superior
Muchas personas tienen la costumbre de lavar las latas de refresco o cerveza, aunque a algunos no les parece necesario hacerlo, pues para ellos basta limpiar con alguna prenda rápidamente.

Limpiar la despensa se convirtió en un hábito bastante común para muchas personas durante la pandemia por Covid-19 que se propagó mundialmente en 2020, pues hubo quienes de esta forma se sentía más seguros, ya que pensaban que al tocar los productos se contagiarían con el virus SARS-CoV-2.
Conforme avanzó la emergencia sanitaria se supo que no se transmitía por contacto, sino a través de pequeñas partículas ya sea mediante la tos o el estornudo. Sin embargo, mucha gente siguió con este hábito de limpiar la despensa, especialmente las latas de refresco o cerveza, lo cual ya era algo normal para algunas personas.
Te puede interesar: ¿Cuándo se celebra el Día de Acción de Gracias en 2023?
VIDEO: ¿cuántas bacterias hay en una lata de refresco?
En el video se puede ver como una persona toma una lata de refresco del supermercado y le realiza una prueba de cultivo bacteriano, la cual se utiliza para detectar bacterias perjudiciales que estén dentro o sobre el cuerpo y se prepara en un laboratorio con todas las medidas necesarias para prevenir agentes infecciosos.
Para hacerlo, la persona tomó una muestra de la parte superior de la lata con un hisopo, la primera fue de la bebida sin limpiar, la segunda muestra fue de una lata limpiada únicamente con el suéter de la persona, como mucha gente acostumbra a hacerlo.
La tercera muestra se tomó de una lata de refresco que fue limpiada con una servilleta y la cuarta se tomó de una lata que fue limpiada con 70 por ciento de etanol, mejor conocido como alcohol etílico.
Te puede interesar: VIDEO: Luis Miguel deja concierto en la CDMX en helicóptero
Posteriormente se dejaron las pruebas en incubación a 28°C y los resultados fueron los siguientes:
Prueba 1: Hongos y bacterias

Prueba 2: Algunos hongos y bacterias

Prueba 3 y 4: Sin crecimiento microbiano visible
¿Por qué es importante limpiar las latas?
De acuerdo con la investigadora de salud y seguridad Caitlin Hoff, siempre se deben de limpiar las latas de refresco antes de beber de ellas directamente o a través de un vaso, ya que hay diversos contaminantes desde el momento en que está en el supermercado, hasta que la lata llega al refrigerador.
Y es que tales contaminantes pueden ser diversos, como estafilococos y coliformes, un tipo de bacteria que se encuentra en los intestinos de los animales. En el video algunas personas comentaron que este tipo de productos, debido a los lugares en los que se almacenan, pueden estar en contacto directo con orina de rata, lo cual puede ser mortal, pues transmiten leptospirosis.

Por estos motivos, se recomienda desinfectar las latas de refresco enjuagándolas con agua caliente antes de abrirlas y colocar otro tipo de productos con químicos más agresivos podría resultar perjudicial para la salud si la boca entra en contacto con ellos.
AIHC
EL EDITOR RECOMIENDA



